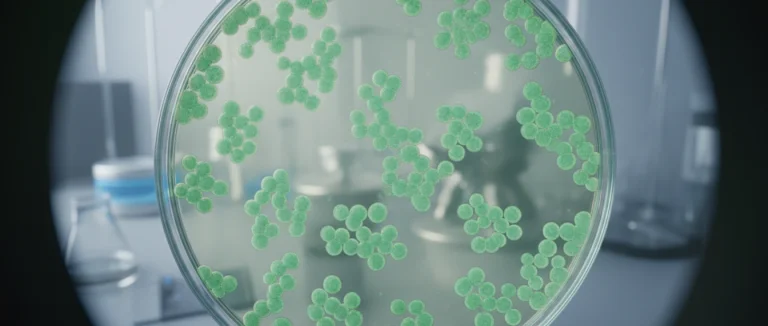
Культура плюрипотентных клеток в чашке Петри

Определение плюрипотентных стволовых клеток и их применение
-
Что такое плюрипотентные стволовые клетки?
-
Как плюрипотентные клетки отличаются от других типов стволовых клеток?
-
Применение плюрипотентных стволовых клеток в медицине
-
Перспективы и вызовы терапии плюрипотентными стволовыми клетками
-
Почему выбирают Лив Хоспитал
В современной биомедицинской науке определение плюрипотентных стволовых клеток стало краеугольным камнем для разработки новых методов лечения. Плюрипотентные клетки способны дифференцироваться во все типы клеток организма, что открывает уникальные возможности для регенеративной терапии. По оценкам экспертов, более 80 % новых клинических исследований в области стволовых клеток опираются именно на плюрипотентные линии.
Эта статья подробно раскрывает, что такое плюрипотентные стволовые клетки, как они соотносятся с другими типами стволовых клеток и какие перспективы открываются перед пациентами, в том числе тем, кто обращается в Лив Хоспитал за передовыми методами лечения.
Мы рассмотрим ключевые понятия, сравним плюрипотентные и мезенхимальные клетки, а также обсудим текущие и будущие применения в терапии, включая лечение онкологических и неврологических заболеваний.
Что такое плюрипотентные стволовые клетки?

Плюрипотентные стволовые клетки – это тип клеток, способный дифференцировать себя в любой из более чем 200 специализированных типов клеток человеческого организма, за исключением плаценты и эмбриональных оболочек. Именно это свойство делает их столь ценными для регенеративной медицины.
Существует два основных источника плюрипотентных клеток:
- Эмбриональные стволовые клетки (ЭСК), получаемые из внутренней клеточной массы бласта.
- Индуцированные плюрипотентные стволовые клетки (iPSC), получаемые пере программированием взрослых соматических клеток.
Оба типа обладают способностью к мультипотентному дифференцированию, однако iPSC позволяют избежать этических вопросов, связанных с использованием эмбрионов.
Таблица 1 демонстрирует основные характеристики этих двух источников.
| Характеристика | Эмбриональные стволовые клетки | Индуцированные плюрипотентные стволовые клетки (iPSC) |
|---|---|---|
| Этические вопросы | Существуют | Отсутствуют |
| Источники получения | Эмбрионы | Соматические клетки взрослых доноров |
| Риск иммунного отторжения | Высокий (при донорстве) | Низкий (при автологичном использовании) |
Плюрипотентные стволовые клетки также активно исследуются в контексте терапии стволовыми клетками, где они могут стать основой для создания тканей и органов «на заказ».
Как плюрипотентные клетки отличаются от других типов стволовых клеток?
Существует несколько категорий стволовых клеток, каждая из которых обладает своим уровнем потенциала дифференцировки. Ключевыми типами являются:
- Тотипотентные клетки – способны образовать только один тип клеток, например, тромбоциты.
- Мультипотентные клетки – способны дифференцировать в несколько, но не все, типы клеток (например, гематоэндоцитарные стволовые клетки).
- Плюрипотентные клетки – способны образовать любой тип соматических клеток.
Для сравнения, в таблице 2 представлены основные отличия плюрипотентных, мезенхимальных и гематопоэтических стволовых клеток.
| Тип клетки | Потенциал дифференцировки | Типичное применение | Источник |
|---|---|---|---|
| Плюрипотентные стволовые клетки | Все соматические типы | Создание органов, регенерация тканей | Эмбрион или iPSC |
| Мезенхимальные стволовые клетки | Костная ткань, хрящ, жир | Ортопедическая регенерация, иммуномодуляция | Костный мозг, жировая ткань |
| Гематопоэтические стволовые клетки | Кровяные клетки всех линий | Трансплантация костного мозга | Костный мозг, периферическая кровь |
Отличие плюрипотентных клеток от мезенхимальных особенно важно в контексте терапии стволовыми клетками при нейродегенеративных заболеваниях, где требуется замена нейронов, а не только поддержка тканей.

Применение плюрипотентных стволовых клеток в медицине
На сегодняшний день плюрипотентные стволовые клетки находятся в центре более чем 300 клинических исследований, охватывающих широкий спектр заболеваний. Ниже перечислены основные направления их применения.
- Регенерация сердечной мышцы после инфаркта.
- Лечение Паркинсона за счёт замещения утраченных нейронов.
- Восстановление кожи при тяжёлых ожогах.
- Создание искусственных органов (печень, почка) для трансплантации.
Особенно перспективным считается использование iPSC в терапии стволовыми клетками для пациентов с редкими генетическими заболеваниями, где традиционные методы лечения не дают результата.
Примером успешного применения является клиническое испытание в Японии, где пациенты с возрастной макулярной дегенерацией получили улучшение зрения после инъекции автологичных iPSC‑клеток.
Таблица 3 суммирует текущие стадии клинических исследований по типам заболеваний.
| Заболевание | Стадия исследования | Тип плюрипотентных клеток | Краткое описание результатов |
|---|---|---|---|
| Сердечная недостаточность | Фаза II | iPSC | Улучшение функции левого желудочка у 60 % пациентов |
| Паркинсон | Фаза I/II | ЭСК | Незначительное восстановление моторных функций |
| Диабет 1 типа | Фаза I | iPSC | Снижение уровня глюкозы у небольшого числа участников |
В Лив Хоспитал уже реализованы пилотные программы по применению плюрипотентных клеток в онкологии, где они используются для создания персонализированных моделей опухолей, позволяющих подобрать оптимальную химиотерапию.
Перспективы и вызовы терапии плюрипотентными стволовыми клетками
Несмотря на огромный потенциал, перед широким внедрением плюрипотентных стволовых клеток остаются серьёзные научные и этические вызовы.
Безопасность и риск опухолевой трансформации
Одним из главных опасений является возможность неконтролируемой пролиферации, что может привести к образованию опухолей. Современные методы генетической модификации и строгий контроль качества позволяют снизить этот риск, однако полностью исключить его пока невозможно.
Этические и регуляторные вопросы
Использование эмбриональных стволовых клеток ограничено в ряде стран, поэтому большинство клиник, включая Лив Хоспитал, предпочитают работать с iPSC, которые обходят эти ограничения.
Технологические барьеры
Процессы масштабирования производства клинически чистых плюрипотентных клеток требуют дорогостоящего оборудования и высококвалифицированного персонала. Кроме того, необходима стандартизация протоколов дифференцировки, чтобы гарантировать воспроизводимость результатов.
Тем не менее, прогресс в области геномного редактирования (CRISPR‑Cas9) и биопечати тканей открывает новые горизонты. Ожидается, что к 2030 году появятся первые полностью функциональные искусственные органы, созданные из плюрипотентных стволовых клеток.
Почему выбирают Лив Хоспитал
Лив Хоспитал – это частная группа аккредитованных JCI больниц в Стамбуле, специализирующаяся на международных пациентах. Мы предоставляем комплексный подход: от записи на приём и организации трансфера до профессионального перевода и помощи с размещением. Наша команда опытных специалистов активно участвует в клинических исследованиях по терапии стволовыми клетками, включая проекты с плюрипотентными стволовыми клетками. Современное оборудование, строгие протоколы качества и индивидуальный подход к каждому пациенту делают нас надёжным партнёром в поиске передовых медицинских решений.
Готовы узнать, как плюрипотентные стволовые клетки могут изменить ваше лечение? Свяжитесь с нашими консультантами уже сегодня, чтобы получить персональную программу обследования и подобрать оптимальный план терапии.
Часто задаваемые вопросы
Плюрипотентные стволовые клетки (PSC) – это уникальная популяция клеток, способная образовывать более 200 специализированных типов клеток человеческого тела. Они могут быть получены из эмбриональной внутренней клеточной массы (ЭСК) или индуцированы из взрослых соматических клеток (iPSC) пере программированием. Благодаря своей способности к мультипотентному дифференцированию, PSC становятся фундаментом регенеративной медицины, позволяя создавать ткани и органы «на заказ». Их применение уже проверяется в клинических исследованиях по лечению сердечной недостаточности, болезни Паркинсона, ожогов и других заболеваний.
* Содержимое нашего сайта предназначено только для информационных целей. Обязательно обратитесь к врачу для диагностики и лечения. В содержание страницы не включены элементы, содержащие информацию о терапевтических медицинских услугах в Лив Госпитале.